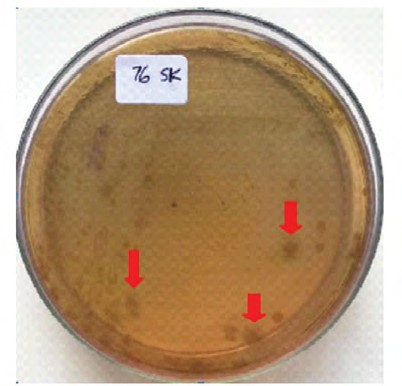

Terapi Oral dan Tetes Mata Topikal pada Green Nail Syndrome
Putti Fatiharani Dewi, Ambar Aliwardani, dkk
Putti Fatiharani Dewi, Ambar Aliwardani, dkk

Terapi Oral dan Tetes Mata Topikal pada Green Nail Syndrome
Sumber: Medicinus Edisi Desember 2021 Volume 34, Issue 3
Putti Fatiharani Dewi, Ambar Aliwardani, Nugrohoaji Dharmawan
Bagian/KSM Ilmu Kesehatan Kulit dan Kelamin
Fakultas Kedokteran Universitas Sebelas Maret, RSUD Dr. Moewardi, Surakarta
Abstrak
Latar belakang: Green nail syndrome merupakan salah satu kejadian kromonikia yang disebabkan oleh bakteri Pseudomonas aeruginosa, dan ditandai dengan onikolisis serta diskolorisasi berwarna hijau kehitaman. Belum terdapat laporan mengenai insiden green nail syndrome di Indonesia. Faktor predisposisi terjadinya green nail syndrome antara lain onikomikosis, aktivitas tinggi pada kondisi yang lembap, diabetes melitus, dan kondisi imunosupresi. Kasus: Seorang laki-laki berusia 51 tahun datang dengan keluhan utama bercak hitam kehijauan di area kuku jari tangan. Pemeriksaan dermatologi pada regio unguium digiti 1,3 dextra et unguium digiti 1 sinistra tampak patch hiperpigmentasi multipel disertai onikodistrofi. Pada pemeriksaan dermoskopi terlihat pigmentasi berwarna hijau kehitaman pada distolateral kuku. Dari biakan kultur bakteri dengan media agar MacConkey didapatkan koloni pigmen berwarna coklat kehijauan. Pasien diobati dengan ciprofloxacin 500 mg/hari serta pengobatan topikal dengan tetes mata polymyxin B 2 kali sehari selama 3 minggu dan menunjukkan perbaikan lesi. Diskusi: Diagnosis green nail syndrome dapat ditegakkan berdasarkan anamnesis, pemeriksaan fisik, serta kultur bakteri yang menunjukkan gambaran khas. Faktor predisposisi pada kasus ini adalah kebiasaan pasien dalam mencuci tangan hingga lebih dari sepuluh kali sehari. Terapi menggunakan tetes mata topikal membantu penyerapan bahan aktif ke dalam kuku.
Kata kunci: green nail syndrome, kromonikia, Pseudomonas aeruginosa
Abstract
Background: Green nail syndrome is one of the chromonychia caused by infection of Pseudomonas aeruginosa, characterized by onycholysis and greenish-black discoloration of the nail. There were no reports regarding the incidence of green nail syndrome in Indonesia. Predisposing factors for the occurrence of green nail syndrome include onychomycosis, high activity in moist and wet conditions, diabetes mellitus, and immunosuppression. Case: A 51-year-old man complained about greenish-black discoloration on his fingernails. Dermatological examination in 1st and 3rd digit of the right hand, as well as 1st digit of the left hand, found multiple greenish-black discoloration with onychodystrophy. Dermoscopy examination of the affected nails showed greenish-black pigmentation in the distolateral nails with peripheral fading. Culture examination using MacConkey agar showed colonies of greenish-brown pigments. The patient was diagnosed with green nail syndrome and treated with ciprofloxacin 500 mg/day and topical polymixin B eye drops b.i.d. for 3 weeks, resulting in good outcome. Discussion: The diagnosis of green nail syndrome is made based on anamnesis, physical examination, and bacterial culture. showing a distinctive feature. The predisposition factor in this case, is the frequent washing hands habit of the patient up to more than ten times per day. Treatment using topical eye drops facilitates the absorption of active ingredients into the nails.
Keywords: green nail syndrome, Pseudomonas aeruginosa, chromonychia
Pendahuluan
Perubahan warna kuku (kromonikia) merupakan kelainan warna pada permukaan lempeng kuku atau jaringan subungual. Beberapa pola diskolorasi kuku ini dapat berupa warna hitam, putih, merah, hijau, biru dan kuning. Green nail syndrome merupakan salah satu kromonikia yang disebabkan oleh infeksi bakteri Pseudomonas aeruginosa.1 Pseudomonas aeruginosa termasuk dalam golongan kuman batang Gram negatif yang umumnya tumbuh dalam lingkungan lembab, terutama air dan tanah. Transmisi bakteri ini dapat melalui kontak langsung maupun tidak langsung dengan air. Faktor predisposisi terjadinya green nail syndrome antara lain onikomikosis, penyakit kuku, aktivitas tinggi pada kondisi yang lembab dan basah, diabetes melitus, dan imunosupresi.2,3
Sebuah penelitian retrospektif di Korea yang dilakukan pada 163 pasien dengan kromonikia menemukan bahwa 6,7% pasien mengalami green nail syndrome. Penelitian lainnya yang dilakukan oleh Mc Neil, dkk. (2001) di Australia menemukan adanya jangkitan infeksi Pseudomonas aeruginosa pada pasien pascaoperasi, dengan onikolisis dan onikomikosis sebagai penyebab utama terjadinya infeksi. Belum terdapat laporan mengenai insiden kasus green nail syndrome di Indonesia.1,4
Gambaran klinis green nail syndrome berupa diskolorisasi lempeng kuku berwarna hijau kekuningan, hijau kecoklatan ataupun hijau kehitaman yang dapat disertai paronikia kronis dan onikolisis distolateral. Pada daerah subungual dapat ditemukan deposit hiperkeratotik, sedangkan di sekitar lempeng kuku eritem dapat terlihat adanya skuama yang terasa gatal.5,6
Pemeriksaan penunjang dermoskopi pada kasus ini dapat menunjukkan pigmentasi berwarna hitam kehijauan yang batasnya menghilang pada area tepi lesi.7 Beberapa media dapat digunakan untuk melakukan kultur dan menguji keberadaan koloni Pseudomonas aeruginosa, antara lain: pada media agar darah bakteri ini menunjukkan koloni yang tidak berwarna, pada media agar nutrien tampak koloni berwarna pucat yang dikelilingi oleh warna biru kehijauan, sedangkan pada media agar MacConkey tampak koloni berwarna kuning pucat hingga coklat kehijauan. Ciri khas lain dari kultur Pseudomonas aeruginosa adalah memberikan aroma seperti buah dan pada pengecatan Gram bakteri menunjukkan warna merah muda.8
Penatalaksanaan green nail syndrome dapat berupa terapi oral dan topikal, namun studi mengenai efektivitas terapi ini masih terbatas. Beberapa laporan kasus menyebutkan bahwa terapi dengan fluoroquinolone oral dan aminoglycoside topikal dinilai efektif dalam penyembuhan lesi.3
Kasus
Tn. M, seorang pria berusia 51 tahun yang bekerja sebagai petani, datang ke Poliklinik Kulit dan Kelamin RS Dr. Moewardi, Surakarta dengan keluhan utama berupa muncul bercak hitam kehijauan di beberapa area kuku yang muncul sejak 2,5 tahun lalu. Dari hasil autoanamnesis riwayat penyakit saat ini, bercak berwarna hitam kehijauan yang awalnya terasa nyeri tersebut muncul pada kuku jari pertama dan ketiga tangan kanan. Pasien memeriksakan diri ke Puskesmas kemudian mendapatkan obat minum serta salep ketoconazole selama enam bulan, namun keluhan tidak juga berkurang. Enam bulan kemudian, muncul keluhan yang sama di daerah jari kuku pertama tangan kiri. Pasien kembali mendapatkan obat antijamur namun keluhan tidak juga berkurang. Pasien akhirnya memeriksakan diri ke RSUD Dr. Moewardi karena keluhan bercak hitam kehijauan serta nyeri tersebut belum juga membaik. Pasien mempunyai kebiasaan sering mencuci tangan dengan air karena merasa tangannya sering kotor. Dalam sehari, pasien bisa mencuci tangan dan kaki lebih dari sepuluh kali. Tidak ada anggota keluarga pasien yang mengalami sakit serupa sebelumnya.
Pada pemeriksaan dermatologis didapatkan pada regio unguium digiti 1, 3 dekstra et unguium digiti 1 sinistra tampak patch hiperpigmentasi multipel disertai onikodistrofi (Gambar 1). Berdasarkan anamnesa dan hasil pemeriksaan fisik, diagnosa banding pasien tersebut adalah green nail syndrome, onikomikosis dan melanonikia.

Gambar 1. Pada regio unguium digiti 1,3 dextra et digiti 1 sinistra tampak patch hiperpigmentasi kehijauan multipel disertai onikodistrofi (panah merah).
Pemeriksaan penunjang dengan dermoskopi pada regio unguium digiti 1 dextra et sinistra menunjukkan adanya pigmentasi berwarna hijau kehitaman pada distolateral kuku (Gambar 2). Pada pemeriksaan KOH 10% yang diambil dari potongan kuku dengan bercak, tidak ditemukan pertumbuhan spora atau hifa. Kultur bakteri dilakukan dengan media MacConkey menggunakan spesimen dari swab dasar kuku. Pengamatan makroskopis tampak koloni filamen berwarna coklat kehijauan, dengan aroma seperti buah, gambaran tersebut sesuai untuk koloni bakteri Pseudomonas aeruginosa (Gambar 3).

Gambar 2. Pemeriksaan dermoskopi. Tampak pigmentasi berwarna hijau kehitaman pada lateral kuku (panah merah)
Gambar 3. Hasil pemeriksaan kultur pada media agar MacConkey dari swab dasar kuku didapatkan koloni pertumbuhan Pseudomonas aeruginosa berwarna coklat kehijauan (panah merah).
Dari hasil anamnesis, pemeriksaan fisik, dan pemeriksaan mikrobiologi berupa kultur bakteri, pasien ini didiagnosis dengan green nail syndrome. Pasien diterapi dengan ciprofloxacin 500 mg/hari dan tetes mata polymyxin B 2x1 tetes per hari pada kuku yang terkena bercak selama tiga minggu. Tampak perbaikan pada lesi pasien setelah pengobatan selama 3 minggu (Gambar 4).

Gambar 4. Pemeriksaan klinis setelah 3 minggu terapi, tampak pigmentasi hijau kehitaman menghilang (lingkaran merah)
Diskusi
Pada kasus ini, pasien mengeluhkan adanya perubahan warna kuku hitam kehijauan sejak 2,5 tahun lalu yang terkadang disertai rasa gatal dan nyeri. Beberapa faktor risiko yang dapat memengaruhi terjadinya green nail syndrome antara lain trauma minor berulang, aktivitas yang tinggi pada kondisi lembap dan basah, onikotilomania, psoriasis, diabetes melitus, serta imunosupresi.9 Faktor risiko yang didapatkan pada pasien ini adalah pekerjaannya sebagai petani yang terpapar tanah lembap serta kebiasaan pasien untuk mencuci tangan menggunakan air dan sabun lebih dari sepuluh kali per hari.
Pemeriksaan dermatologi pada lempeng kuku terlihat ujud kelainan kulit berupa regio unguium digiti 1,3 dextra et unguium digiti 1 sinistra tampak diskolorisasi kuku berwarna hijau kehitaman disertai onikodistrofi yang mengarah pada green nail syndrome. Penegakan diagnosis ditunjang dengan hasil pemeriksaan dermoskopi dan kultur bakteri. Pada pasien ini dilakukan kultur menggunakan agar MacConkey dengan spesimen dari swab dasar kuku, di mana kemudian didapatkan hasil pengamatan makroskopik berupa adanya koloni filamen berwarna coklat kehijauan.
Warna kehijauan disebabkan oleh pigmen pyoverdine dan pyocyanin yang dihasilkan oleh bakteri Pseudomonas aeruginosa. Pigmen pyoverdine berfungsi sebagai transporter besi dari lingkungan untuk reseptor membran bakteri, sedangkan pigmen pyocyanin merupakan metabolit sekunder aktif penghasil pigmen biru kehijauan yang dapat digunakan untuk diagnosis cepat infeksi Pseudomonas aeruginosa. Pada kuku pasien juga ditemukan onikodistrofi pada bagian kuku yang terkena. Onikodistrofi sendiri terjadi karena adanya kolonisasi bakteri yang dapat merusak permukaan keratin kuku.4
Diagnosis infeksi Pseudomonas aeruginosa ditegakkan dari isolasi dan identifikasi bakteri melalui pemeriksaan laboratorium. Pada pasien ini spesimen diambil dari swab yang diambil dari dasar kuku. Pseudomonas aeruginosa dapat tumbuh pada sebagian besar media. Beberapa media yang biasanya digunakan untuk menumbuhkan koloni bakteri Pseudomonas aeruginosa antara lain adalah media agar darah, agar nutrien, agar MacConkey, dan media kromogenik.8 Media MacConkey sering digunakan sebagai media kultur koloni Pseudomonas aeruginosa karena sifatnya yang selektif terhadap pertumbuhan bakteri Gram negatif serta memberikan gambaran yang cukup khas untuk bakteri Pseudomonas aeruginosa.10
Diagnosis banding pada pasien ini dapat berupa keadaan melanonikia, yang meliputi: melanoma kuku dan nevus. Kondisi infeksi yang dapat menyebabkan diskolorisasi kuku adalah onikomikosis.1 Untuk menyingkirkan diagnosis banding dapat menggunakan pemeriksaan sederhana menggunakan dermoskopi. Pada melanoma kuku, pemeriksaan dermoskopi menunjukkan adanya pigmen kehitaman dengan batas yang tidak jelas dan pigmentasi dapat meluas hingga ke daerah periungual. Gambaran mikroskopis pada nevus dapat berupa pigmentasi yang berbentuk garis longitudinal. Pada onikomikosis dapat dijumpai gambaran dermoskopi berupa pigmen kekuningan disertai skuama dan onikodistrofi. Selain itu, pemeriksaan dengan KOH akan menunjukkan hasil positif.11,12 Pada pemeriksaan KOH pada pasien ini tidak dijumpai adanya hifa.
Modalitas terapi pada green nail syndrome meliputi pemberian antibiotik, baik sistemik dan/atau topikal. Antibiotik yang sensitif terhadap Pseudomonas aeruginosa meliputi aminoglycosides (gentamicin, amikacin, tobramycin), quinolones (ciprofloxacin, levofloxacin) polymyxin B, dan bacitracin. Terapi oral menggunakan ciprofloxacin 500 mg/hari selama 3 minggu memberikan hasil yang baik. Terapi ini dikombinasi dengan menggunakan obat topikal berbentuk tetes mata untuk meningkatkan penyerapan obat dengan lebih baik ke area diskolorisasi kuku.3,13 Pada pasien ini diberikan terapi oral dengan ciprofloxacin 500mg/hari dan tetes mata polymyxin B sebagai terapi topikal. Terdapat perbaikan pada lesi setelah 3 minggu terapi. Pemilihan modalitas terapi polymyxin B didasarkan pada bukti aktivitasnya yang efektif sebagai bakterisidal pada bakteri Gram negatif, termasuk Pseudomonas aeruginosa, meskipun penelitian farmakokinetik dan farmakodinamik agen ini sangat terbatas karena penggunaan klinisnya yang relatif sedikit.14 Penggunaan terapi kombinasi oral dan topikal tetes mata selama 3 minggu pada pasien ini memberikan efek perbaikan pada lesi, disertai dengan edukasi untuk menghindari faktor pemicu yaitu frekuensi mencuci tangan yang terlampau sering, serta menghindarkan diri dari kegiatan yang berkontak lama dengan kelembapan.
Kesimpulan
Telah dilaporkan satu kasus green nail syndrome pada seorang laki-laki berusia 51 tahun. Diagnosis ditegakkan berdasarkan hasil anamnesis, pemeriksaan fisik, pemeriksaan dermoskopi, dan pemeriksaan kultur. Pemeriksaan fisik didapatkan pada regio unguium digiti 1,3 dextra et unguium digiti 1 sinistra tampak patch hiperpigmentasi multipel disertai onikodistrofi. Pada pemeriksaan dermoskopi tampak gambaran pigmentasi hijau kehitaman pada bagian distolateral kuku. Pemeriksaan kultur bakteri menggunakan media MacConkey dengan mengambil spesimen dari swab dasar kuku, secara makroskopis tampak koloni filamen berwarna coklat kehijauan dengan karakteristik fruity odor yang sesuai dengan karakteristik koloni Pseudomonas aeruginosa. Terapi dengan obat oral ciprofloxacin 500 mg/hari dan tetes mata polymyxin B 2 kali sehari selama 3 minggu menghasilkan perbaikan lesi yang bermakna.
DAFTAR PUSTAKA